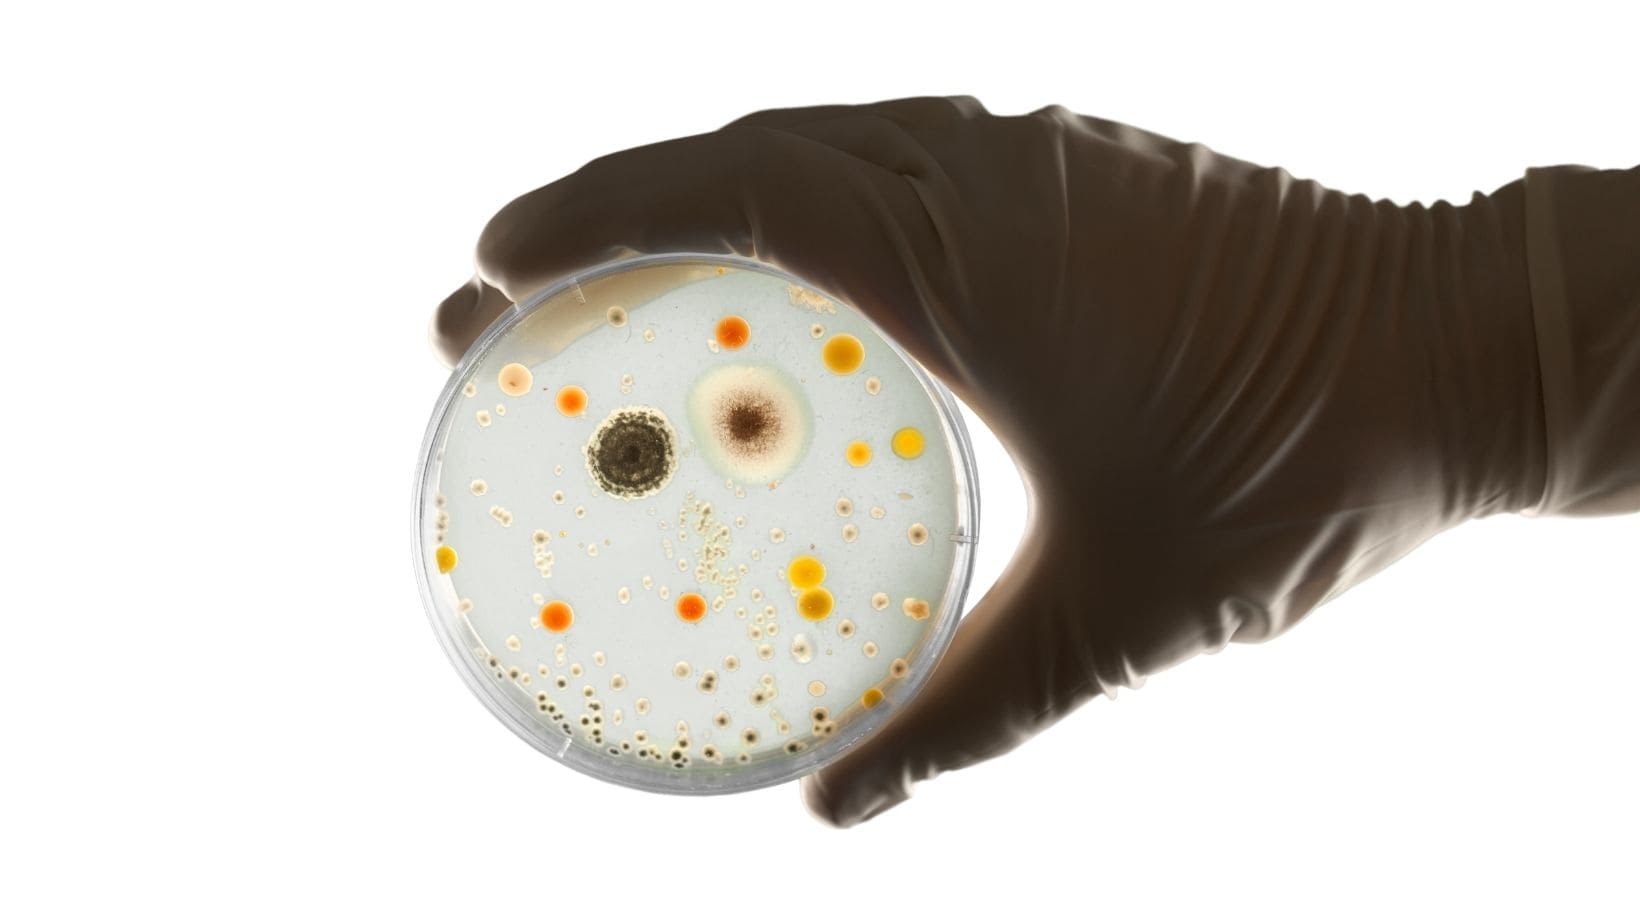
Faut-il être pour ou contre les conservateurs?

J'entends régulièrement des débats concernant les conservateurs. Ces derniers sont parfois décriées. Faut-il être pour ou contre les conservateurs. Nous allons faire le tour de la question ....
Quand doit on utiliser un conservateur ? Lorsqu’un produit contient de l’eau ou une phase aqueuse, un conservateur doit être ajouté. Il va empêcher une prolifération de micro-organismes tels que les bactéries, moisissures, levures et champignons. Tous les micro-organismes ne sont pas dangereux. Prenez par exemple les bactéries nécessaires pour préparer le fromage, les levures avec lesquelles on prépare les bières ou les bactéries présentes dans nos intestins, nécessaires à notre digestion….
Par contre, le conservateur servira à protéger les produits de micro-organismes qui peuvent faire tourner, changer la couleur ou la texture d’un produit, être néfastes pour la peau ou voir dangereux pour le consommateur dans certains cas. Le produit peut être contaminé dès sa production, pendant le conditionnement ou par le consommateur, lorsque celui-ci introduit ses doigts dans un pot, il peut y introduire des milliers de micro-organismes. La lumière, la poussière et la température peuvent être des facteurs aggravants. Il existe différents types de conservateurs :
- Les conservateurs synthétiques Rien de similaire n’existe dans la nature. Ils sont souvent fabriqués à partir d’huile minérales ou autres substances chimiques
- Naturel identique : cela signifie que ces conservateurs peuvent être retrouvés dans la nature mais sont répliqués et synthétisés dans un laboratoire
- Dérivés du naturel : dans ce cas, le conservateur est préparé à partir d’une base naturelle mais modifiée en laboratoire par le biais de réactions chimiques telles que la fermentation, l’estérification ou l’hydrolyse
- Les conservateurs naturels : dans ce cas, les conservateurs sont 100% naturels et ils ne sont pas modifiés
C’est important qu’un produit contenant de l’eau soit bien conservé. Nous l’avons vu plus haut, ça peut être dangereux pour le consommateur d’appliquer un soin mal conservé et contaminé. Cependant, tous les conservateurs ne sont pas à mettre à la même enseigne et certains comportent des problématiques. Il est assez difficile de préserver un soin pour une longue période avec un conservateur naturel. Si vous voyez un petit pot avec une date comme ![]() 3M, 6M ou 12M, cela signifie que votre produit peut être conservé pendant plus de 30 mois et ensuite 3, 6 ou 12 mois après ouverture. Ça peut vous donner une indication que le conservateur présent dans le produit est puissant. De plus, un soin qui a été produit il y a plus de 3 ans n’aura plus vraiment d’actifs. Faites également attention à la mention « sans parabène ». Elle est souvent utilisée comme argument marketing.
3M, 6M ou 12M, cela signifie que votre produit peut être conservé pendant plus de 30 mois et ensuite 3, 6 ou 12 mois après ouverture. Ça peut vous donner une indication que le conservateur présent dans le produit est puissant. De plus, un soin qui a été produit il y a plus de 3 ans n’aura plus vraiment d’actifs. Faites également attention à la mention « sans parabène ». Elle est souvent utilisée comme argument marketing.
Comme les parabènes ont mauvaise presse, ils ont été remplacés par d’autres conservateurs qui sont, dans certains cas pires que les parabènes. Voici une liste non exhaustive des conservateurs controversés que l’on retrouve dans les cosmétiques conventionnels, qu'il faut éviter car ils peuvent poser des problématiques pour la santé:
- Methylisothiazolinone et Methylchloroisothiazolione
- Benzophenone
- Phenoxyethanol
- BHA et BHT Butylated hydroxyanisole (BHA) Butylated hydroxytoluene (BHT)
- Les Parabens Parahydroxybenzoate propyl et Butylparaben Potassium propyl paraben Sodium propyl paraben Methly parabène…. En règle générale tous ceux qui sont accompagnés de "paraben". Certains semblent néanmoins moins dangereux. Un moyen mnémotechnique que recommande "Que choisir" est d'éviter absolument ceux qui commencent par "P" ou "B"
- Formaldéhide (ou formol) ou libérateurs de fomaldéhide: DMDM hydantoinDiazolidinyl Imidazolidinyl ureaMethenamineQuarternium -15
- Triclosan
- Acides organiques Acide benzoïque et ses sels, acide sorbique et ses sels, acide salicylique, acide levulinique et ses sels, acide p-anisique et ses sels, acide citrique, unisique acide et acide déhydroacétique
- Phénols : polyphénols et flavanoids Lonicerin, Totarol
- Terpènes : Diterpènes, Triterpènes Terpinen-4-ol dans l’arbre à thé
- Aldéhydes aromatiques et alcools aromatiques Phenethyl alcohol, benzyl alcohol, piperonal (heliotropin)
- Métaux Silver salts (silver chloride, silver citrate), and colloidal silver derivatives, Zinc, Ricinoleate, Zinc PCA
- Enzymes
- Structures complexes Ferments tels que Lactoperoxidase, Lactobacillus
- Esthers et acides organiques Glyceryl caprylate, glyceryl caprate
Pour le consommateur, ça n’est pas forcément évident de se retrouver. Le plus simple est déjà de retenir les conservateurs néfastes et de vous référer au site « La vérité sur les cosmétiques » en cas de doute. Une journaliste indépendante y a développé un moteur de recherche qui permet de s’informer sur un composant cosmétique particulier ou de déterminer le profil complet d’un produit. Du côté de &THE GREEN, nous sommes des obsédés des ingrédients et avons une transparence totale sur tous nos produits. Nous détaillons la liste des composants pour chaque produit et nous engageons à n’utiliser que des ingrédients qui correspondent à l’évaluation « très bien » ou « bien » dans la base de données. de https://laveritesurlescosmetiques.com/ En ce moment, nous avons 3 produits qui contiennent une phase aqueuse. Il s’agit des hydrolats. L'hydrolat de rose est conservé avec le conservateur naturel nommé Leucidal Complete.
Le Leucidal Liquide Complet est une structure complexe, contenant des peptides antimicrobiens. Un des peptides antimicrobiens est à l'origine dérivée des bactéries lactiques Leuconostoc kimchii un type de chou fermenté. L'autre type de peptide antimicrobien et anti-fongique, est créé à partir de fermentation de la noix de coco avec le Lactobacillus. L’hydrolat de menthe poivrée et de fleur d’oranger, quant à eux, contiennent eux un mélange de sodium benzoate et potassium sorbate, agrées par les labels bio.